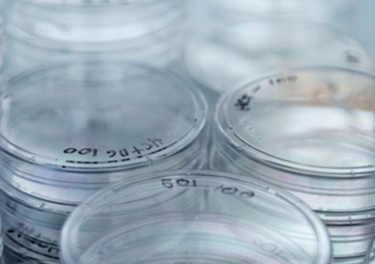
work image

Life is the art of drawing without an eraser.1
Rubén D. Mercado is a senior creative marketing leader and musician based in Boulder, CO. Born and raised in El Barrio section of New York, salsa music, wall murals and graffiti became the inspiration for a career in the arts.
Throughout his 15+ years in the field, his goal has always been to ensure the smoothest workflow and highest quality from concept to completion and delivery. His collaborative and organizational skills make it possible for him to seamlessly liaise with clients, strategy, creative and account management.
He has had the honor of working with numerous institutions including, The United Nations, Mount Sinai Medical Center, New York Theatre Workshop, NYC Parks Department, McKinsey Solutions, NASDAQ and Novartis Pharmaceuticals.
Download a copy of my resume and client list.
You are the music while the music lasts.3
1. John W. Gardner 2. Leonardo da Vinci 3. T.S. Eliot